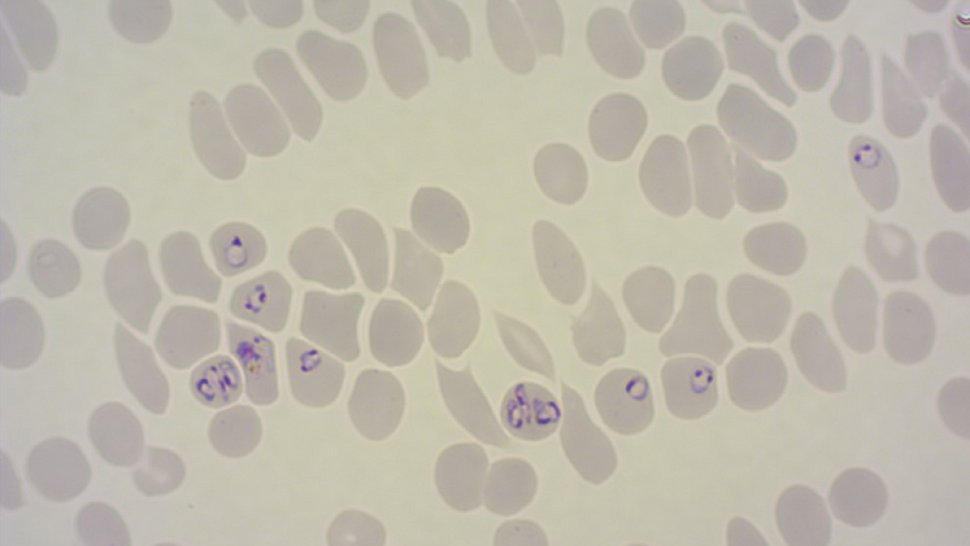
Die mikroskopische Aufnahme zeigt rote Blutkörperchen, von denen einige mit Malariaparasiten befallen sind.

Malaria verstehen: Forschende des BNITM entwickeln innovative Methode
Rote Blutkörperchen, die mit dem Malariaparasiten infiziert sind, heften sich an Blutgefäße. Je stärker dies geschieht, desto mehr Komplikationen treten während der Malariaerkrankung auf. Dies ist bekannt, und verantwortlich dafür ist das Parasitenprotein PfEMP1. Wissenschaftler:innen des Bernhard-Nocht-Instituts für Tropenmedizin (BNITM) haben nun ein innovatives System entwickelt, um PfEMP1 besser untersuchen zu können. Damit versprechen sich die Forschenden ein besseres Verständnis der Malariaerkrankung und langfristig neue Therapieansätze. Die Ergebnisse erschienen kürzlich als begutachtete Vorabpublikation in der Fachzeitschrift eLife.
Der Malariaparasit Plasmodium falciparum kann das Protein „Plasmodium falciparum erythrocyte membrane protein 1“ (PfEMP1) in großer Vielfalt herstellen. Jeder Parasit verfügt in seiner Erbinformation über etwa 60 verschiedene Varianten von PfEMP1. Er stellt aber zu einem Zeitpunkt nur eine Variante als Protein her. Diese Parasiten wechseln während einer Infektion zwischen den Varianten, um dem Immunsystem zu entgehen. Die Vielfalt an PfEMP1-Varianten erschwert es den Forschenden erheblich, einzelne Varianten zu untersuchen: In Zellkulturen stellt eine Population an Malariaparasiten nicht nur eine, sondern gleichzeitig mehrere Varianten her. Dadurch lassen sich die Eigenschaften einzelner Varianten nur schwer studieren.

Mit einer in der Arbeitsgruppe vorher entwickelten Methode namens „Selection Linked Integration“ (SLI) (Birnbaum et al., 2017 NatMethods) ist es den Forschenden gelungen, Parasitenpopulationen zu erzeugen, die ausschließlich eine spezifische PfEMP1-Variante produzieren.
„Dies ermöglicht uns unter anderem, präzisere Einblicke in die Rolle von PfEMP1 bei der Zytoadhäsion, also der Anhaftung infizierter Zellen an die Innenwand der Blutgefäße, zu gewinnen“, erläutert Jakob Cronshagen, Erstautor der Studie.
Neue Methode ermöglicht die Beantwortung vielfältiger Fragestellungen
Das SLI-System lässt sich effektiv einsetzen, um wesentliche Aspekte der Funktion von PfEMP1 zu untersuchen. Die Forschenden analysierten zum Beispiel die Transportwege des PfEMP1-Proteins innerhalb infizierter roter Blutkörperchen. Auch charakterisierten sie die Bindungseigenschaften der verschiedenen PfEMP1-Varianten an menschliche Rezeptoren. Eine weiterentwickelte Version der SLI-Methode, SLI2, ermöglichte es dem Forscherteam, zusätzliche genetische Modifikationen in bereits veränderten Parasiten durchzuführen. Mit diesem Ansatz konnten die Forschenden zwei bislang unbekannte Proteine identifizieren, die in den Prozess der Zytoadhäsion involviert sind.
„Unsere Ergebnisse eröffnen neue Möglichkeiten, den Mechanismus der Malariapathogenese zu entschlüsseln“, erklärt Dr. Tobias Spielmann, Leiter der Arbeitsgruppe Malaria-Zellbiologie am BNITM. „Die gewonnenen Erkenntnisse könnten langfristig zur Entwicklung neuer therapeutischer Ansätze führen, die gezielt die Zytoadhäsion der Parasiten unterbinden.“
Weiterführende Informationen
Pressemitteilung des eLife-Journals
Originalpublikation: Cronshagen J. et al. “A system for functional studies of the major virulence factor of malaria parasites.” eLife 2024
Mit dem Artikel in Verbindung stehende Publikation: Birnbaum J.et al. “A genetic system to study Plasmodium falciparum protein function.” Nat Methods 2017
Ansprechperson
Dr. Tobias Spielmann
Research group leader
Telefon : +49 40 285380-486
E-Mail : spielmann@bnitm.de
Dr. Anna Hein
Presse- & Öffentlichkeitsarbeit
Telefon : +49 40 285380-269
E-Mail : presse@bnitm.de